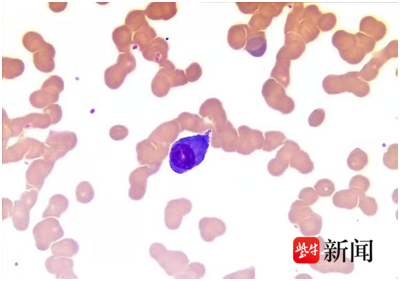

一张血片揪出多发性骨髓瘤,江大附院紧急寻人守护血液病患生命
来源: 紫牛新闻
2026-03-18 21:16:00
扬子晚报网3月18日讯(通讯员 孙卉 钱小蔷 记者 姜天圣)在血液科的诊疗中,有这样一种恶性肿瘤,它早期症状隐匿,极易被忽视,被称为“沉默的杀手”,它就是多发性骨髓瘤。近日,镇江市江大附院(江滨医院)医护团队凭借专业的敏锐度、高效的协作力,从一张异常血片入手,层层排查、紧急寻人,成功揪出这个隐藏的“杀手”,上演了一场与时间赛跑的生命守护战。
实验室的敏锐发现
一张血片锁定可疑目标
2月5日下午16:21,江大附院血液病实验室内,检验技师吴绘娜在审核门诊的一张血片时发现了异常:镜下的细胞高度疑似浆细胞,这一特殊表现让她立刻警觉起来。凭借职业敏感度,她第一时间将血片情况反馈给血液病实验室主任蒋茜,希望得到专业复核。
血片
彼时,蒋茜主任正赶往外地医院参与评审,收到消息后立刻停下脚步查看。“浆细胞清晰可见,红细胞还呈现出典型的缗钱状排列,结合患者69岁年龄、血常规提示单系贫血的基本情况,脑海中瞬间闪过一个诊断——多发性骨髓瘤?”为了进一步验证判断,蒋主任立刻询问相关生化检查结果,在得知暂未完善后,她当即叮嘱吴绘娜先按规定发报告,自己则第一时间联系上接诊该患者的血液科主任医师陆益龙,将血片的异常发现和初步判断同步告知,一场针对这一可疑病例的诊疗联动,就此开启。
陆主任接到电话后回忆起这位患者:单系贫血,白细胞、血小板均正常,红细胞体积无异常,贫血原因始终不明。外院检查仅提示白蛋白低,肾功能无异常,此前已为患者开具血尿常规、血片检查、补体免疫球蛋白轻链全套等相关检查。
收到蒋主任的提示后,陆主任表示会密切关注患者的各项检查结果,做好后续诊疗准备。

现场
紧急寻人
多岗接力争取救治时间
2月6日上午10:27,患者的免疫球蛋白检查结果出炉,IgG明显升高,结合此前的血片异常,高度提示为多发性骨髓瘤,急需返院复诊并完善进一步检查以明确诊断,开展后续治疗。
按照诊疗安排,患者本应当日来院,可时间一分一秒流逝,直至下午下班,始终未见患者身影。陆主任多次拨打患者预留的手机号码,却始终无法接通。这一情况,让所有人的心都悬了起来——多发性骨髓瘤本就进展隐匿,若错失诊疗时机,病情持续发展将严重影响生存期和生活质量,甚至危及生命。
2月7日一早,陆主任再次尝试联系患者,电话依旧无法接通。内科门诊护士杨云立即联系警方,请民警帮忙联系患者家属。
在警方的协助下,终于联系上了患者家属,并顺利找到患者,第一时间为其安排了住院,完善后续检查,让患者得到了及时、规范的诊疗干预。
发病率居血液肿瘤第二位
早期几乎无明显症状
大多数人对白血病、淋巴瘤并不陌生,却对多发性骨髓瘤知之甚少,而这一疾病,正成为威胁中老年人健康的 “隐形杀手”。它是骨髓内克隆性浆细胞异常增生的血液系统恶性肿瘤,发病率位居血液肿瘤第二位,仅次于淋巴瘤,发病年龄多在50-60岁,40岁以下少见,男女患病比例约为3:2。
多发性骨髓瘤被称为“沉默的杀手”,核心原因是早期几乎无明显特异性症状,90%以上的患者首发表现为不同程度的贫血,且贫血会随病情进展不断加重,这也是本次69岁患者的首发症状。
除此之外,部分患者还会出现这些易被忽视的表现:不明原因骨痛,常被误认为骨质疏松,严重时还会出现反复骨折;肾功能异常,易被误诊为肾病,前往肾内科就诊;反复感染,如呼吸道、泌尿系统感染,甚至引发败血症,因正常免疫球蛋白合成受抑,患者免疫力大幅下降;乏力、出血倾向、高钙血症等。
值得一提的是,细胞形态学检查在多发性骨髓瘤的诊断中起着关键作用,如本次病例中,正是血片检查发现的浆细胞和红细胞缗钱状排列,为早期诊断提供了重要线索。
医生提醒,大家也无需对多发性骨髓瘤过度恐惧,如今针对这一疾病的治疗手段已经非常成熟,只要及时明确诊断,接受正规、系统的治疗,患者大多能获得良好的治疗效果,拥有长期且有质量的生活。
校对 朱亚萍